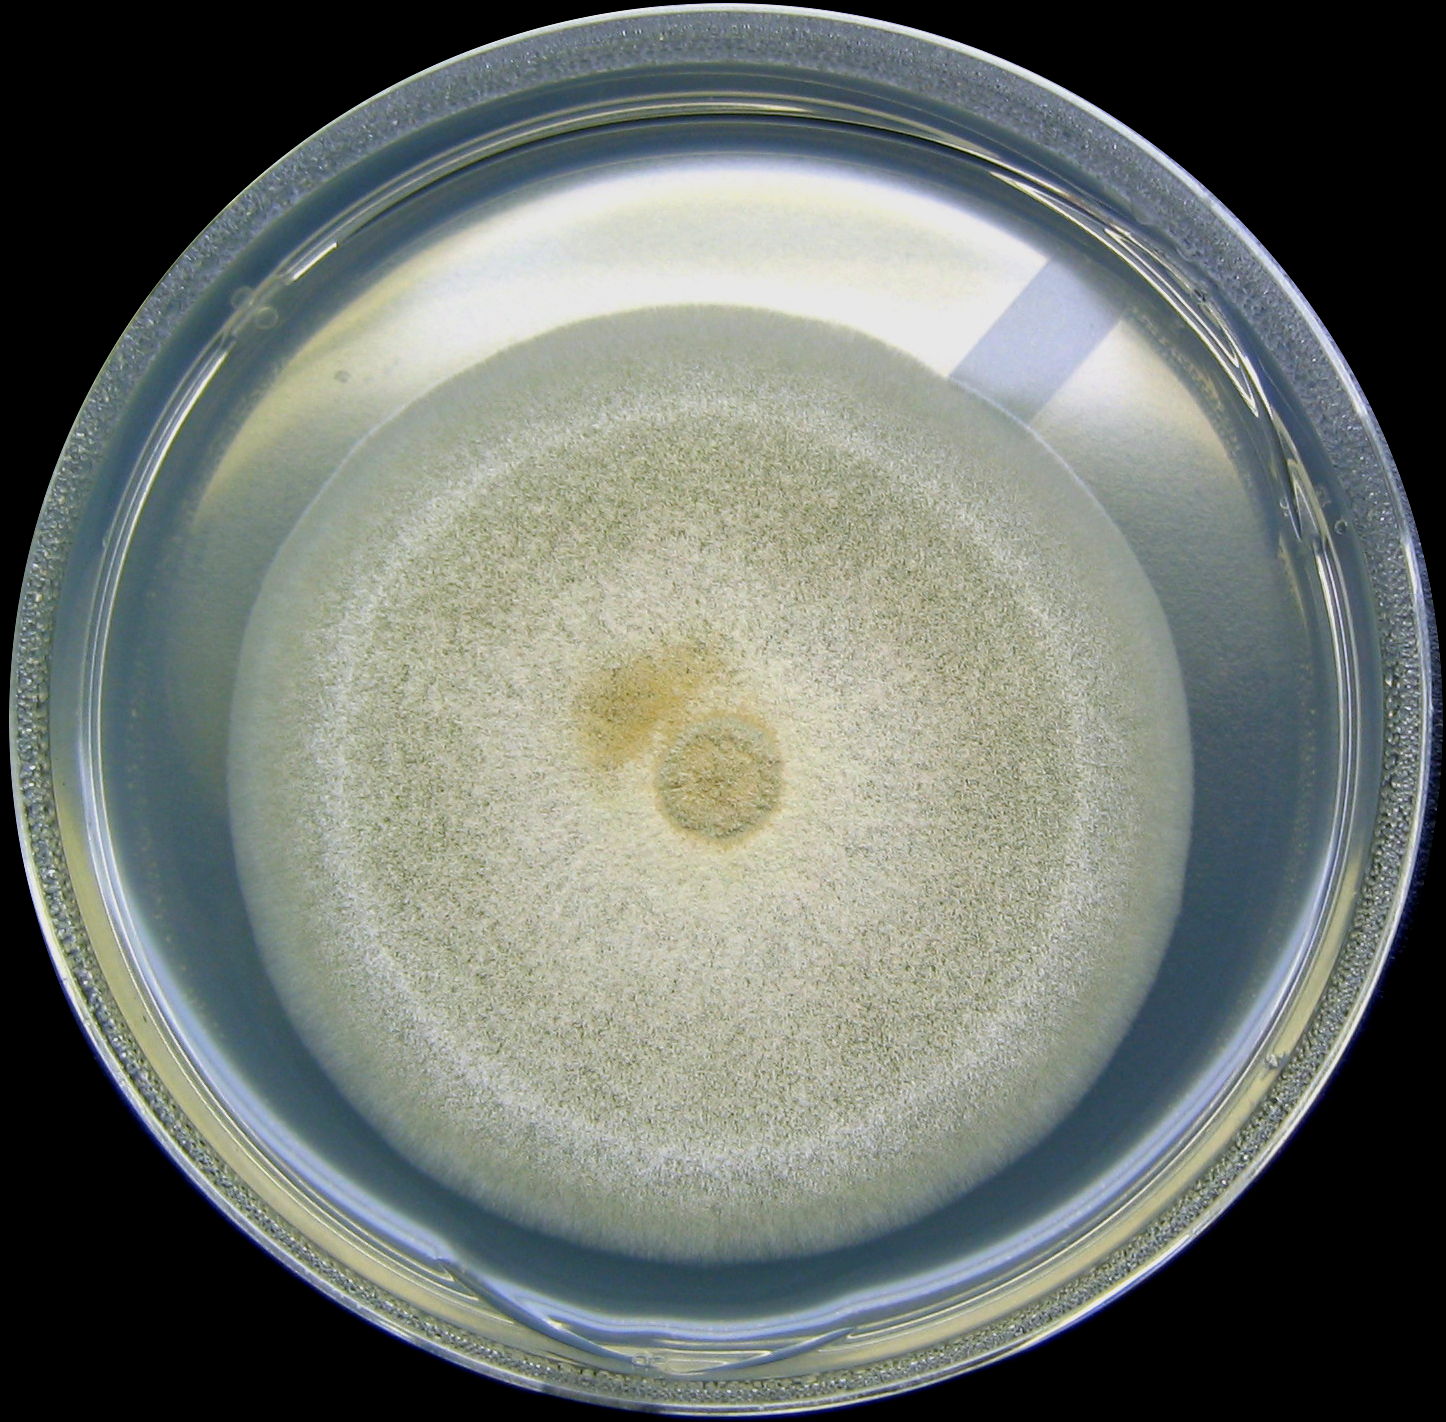

프로피오닐-CoA
"오늘의AI위키"의 AI를 통해 더욱 풍부하고 폭넓은 지식 경험을 누리세요.
1. 개요
프로피오닐-CoA는 다양한 대사 경로에서 생성되는 3탄소 화합물로, 홀수 지방산의 산화, 특정 아미노산의 산화, 콜레스테롤 산화 과정 등에서 생성된다. 포유류에서는 프로피오닐-CoA 카복실화효소에 의해 메틸말로닐-CoA로 전환된 후 석시닐-CoA로 전환되어 시트르산 회로에 참여한다. 프로피오닐-CoA의 축적은 생물에 독성을 나타낼 수 있으며, 세균과 식물, 균류에서도 다양한 대사 작용에 관여한다. 특히, 프로피오닐-CoA 카복실화효소 결핍은 프로피온산혈증을 유발하여 신생아의 발달 장애를 초래할 수 있으며, 단백질 프로피오닐화 반응의 기질로 작용하기도 한다.
더 읽어볼만한 페이지
- 조효소 A의 싸이오에스터 - 아세틸-CoA
아세틸-CoA는 탄수화물, 지방산, 아미노산 분해 과정에서 생성되어 시트르산 회로, 지방산 대사, 콜레스테롤 합성 등 다양한 생화학 반응에 관여하는 세포 대사에서 중요한 분자이다. - 조효소 A의 싸이오에스터 - 스테아로일-CoA
스테아로일-CoA는 스테아로일-CoA 불포화효소에 의해 생성되는 지방산의 일종이며, 포화 지방산을 불포화 지방산으로 전환하는 효소인 SCD의 활성 변화가 여러 질병과 연관되어 연구 가치가 높다. - 물질대사 - 아라키드산
아라키드산은 탄소 20개로 이루어진 포화 지방산으로, 땅콩 기름과 같은 식물성 기름에 많이 함유되어 있으며, 인체 내에서 세포막 구성, 신호 전달 물질의 전구체, 에이코사노이드 합성에 관여하고, 제약 산업에서 프로스타글란딘의 전구체로 사용되는 경제적 가치가 높은 물질이다. - 물질대사 - 카프릴산
카프릴산은 8개의 탄소로 이루어진 포화 지방산으로, 식품, 향료, 소독제 등 다양한 산업에 사용되며, 식욕 촉진, 항균 작용, 간질 치료 등 의학적 용도로도 연구된다.
프로피오닐-CoA - [화학 물질]에 관한 문서 | |
---|---|
일반 정보 | |
![]() | |
IUPAC 명칭 | 3′-O-Phosphonoadenosine 5′- |
계통명 | O1- |
다른 이름 | 프로피오닐 조효소 A; 프로파노일 조효소 A |
화학식 | C24H40N7O17P3S |
분자량 | 823.60 g/mol |
CAS 등록번호 | 317-66-8 |
UNII | H7HQA57V5H |
PubChem | 439164 |
ChemSpider ID | 21106467 |
ChEBI | 15539 |
SMILES | CCC(=O)SCCNC(=O)CCNC(=O)C(O)C(C)(C)COP(O)(=O)OP(O)(=O)OCC3OC(n2cnc1c(N)ncnc12)[C@H](O)[C@@H]3OP(O)(O)=O |
MeSH 이름 | 프로피오닐-조효소 A |
물리적 성질 | |
외형 | 알려진 바 없음 |
밀도 | 알려진 바 없음 |
녹는점 | 알려진 바 없음 |
끓는점 | 알려진 바 없음 |
위험성 | |
주요 위험 | 알려진 바 없음 |
인화점 | 알려진 바 없음 |
자연 발화점 | 알려진 바 없음 |
참고 문헌 | |
참고 문헌 | Dasgupta, 2019 Wongkittichote, Ah Mew & Chapman, 2017 Upton & McKinney, 2007 Dolan et al., 2018 Shchelochkov, Carrillo & Venditti, 1993 |
2. 생성
프로피오닐-CoA는 여러 대사 경로를 통해 생성된다.
- 프로피오닐-CoA는 3탄소 화합물인 프로피온산의 유도체이다.
- 반추 동물에서 일어나는 홀수 사슬 지방산의 β 산화 과정에서 생성된다.
- 이소류신, 발린, 트레오닌, 메티오닌의 대사 과정에서 생성된다.
- 콜레스테롤 산화 과정에서 담즙산이 형성될 때 부산물로 생성된다.
식물과 곤충에서는 프로피오닐-CoA가 β 산화와 유사한 다른 경로를 통해 아세트산으로 대사된다. 이 경로의 세부 사항은 모두 밝혀지지 않았지만, 아크릴릴-CoA와 3-하이드록시프로피오닐-CoA가 생성되는 것으로 알려져 있다. 이 대사 과정에서 3-하이드록시프로피오닐-CoA의 1-탄소는 이산화 탄소가 되고, 3-탄소는 아세트산의 1-탄소가 된다.
2. 1. 홀수 지방산 산화
홀수 지방산은 산화되어 아세틸-CoA 뿐만 아니라 프로피오닐-CoA도 생성한다. 프로피오닐-CoA는 프로피오닐-CoA 카복실화효소에 의해 (S)-메틸말로닐-CoA로 전환되고, 이어서 비타민 B12를 보조 인자로 사용하는 메틸말로닐-CoA 뮤테이스에 의해 석시닐-CoA로 전환된다.[21] 이 과정에서 탄산수소 이온과 ATP가 필요하다.(S)-메틸말로닐-CoA는 메틸말로닐-CoA 에피머라아제에 의해 (R)-메틸말로닐-CoA로 전환된다. 메틸말로닐-CoA 뮤테이스의 결핍은 혈액의 pH가 감소하는 메틸말론산 혈증(Methylmalonic acidemia)을 유발한다.[19]
생성된 석시닐-CoA는 시트르산 회로의 중간체로 대사된다.
2. 2. 아미노산 산화
프로피오닐-CoA는 메티오닌, 발린, 아이소류신, 트레오닌을 포함하는 아미노산의 산화에 의해 생성된다.[20][1] 또한, 아미노산의 이화작용은 프로피오닐-CoA 카복실화효소에 의한 프로피오닐-CoA의 메틸말로닐-CoA로의 전환 결과일 수도 있다.[20][1]2. 3. 콜레스테롤 산화
콜레스테롤 산화로 담즙산이 형성될 때 프로피오닐-CoA가 부산물로 생성된다. 술드(Suld) 등이 수행한 실험에서 간 미토콘드리아, 조효소 A, 프로피온산을 혼합했을 때, 프로피온산에 표지된 동위 원소가 분해되었다. 그러나 5β-콜레스테인-3α,7α,12α,26-테트롤-26,27-C14의 대사 과정을 추적한 결과 프로피오닐-CoA는 쓸개즙 형성과 함께 발견되었다.[25]3. 대사 운명
프로피오닐-CoA의 대사는 합성되는 환경에 따라 달라진다. 혐기성 호흡 환경에서 프로피오닐-CoA는 호기성 생물에서와 다른 대사 운명을 가질 수 있다. 프로피오닐-CoA 카복실화효소나 메틸시트르산 생성효소에 의한 대사 경로는 다양한 유전자의 존재 여부에 따라 달라진다.[26]
프로피오닐-CoA는 주로 프로피오닐-CoA 카복실화효소 반응과 메틸시트르산 회로를 통해 대사된다. 사람의 경우 프로피오닐-CoA는 프로피오닐-CoA 카복실화효소에 의해 메틸말로닐-CoA로 전환된 후, 석시닐-CoA로 전환되어 시트르산 회로에서 사용될 수 있다. 또한, 프로피오닐-CoA는 옥살아세트산과 상호작용하여 메틸시트르산을 형성할 수 있으며, 이는 메틸시트르산 회로를 통해 피루브산으로 전환될 수 있다.
3. 1. 프로피오닐-CoA 카복실화효소 반응
사람에서 시트르산 회로의 옥살아세트산과 상호작용하여 메틸시트르산을 형성하는 프로피오닐-CoA는 프로피오닐-CoA 카복실화효소에 의해 카복실화되어 메틸말로닐-CoA로 전환될 수 있다. 메틸말로닐-CoA는 나중에 석시닐-CoA로 전환되어 시트르산 회로에서 사용될 수 있다. 프로피오닐-CoA 카복실화효소는 프로피오닐-CoA 뿐만 아니라 여러 다른 아실-CoA들의 카복실화도 촉매하지만, 프로피오닐-CoA에 가장 높은 친화력을 보인다. 프로피오닐-CoA의 전환은 글루탐산과 같은 몇몇 시트르산 회로 대사 산물의 부재에 의해 억제되는 것으로 나타났다.[21][2]3. 1. 1. 작용 기작
포유류에서 프로피오닐-CoA는 비오틴 의존성 효소인 프로피오닐-CoA 카복실화효소에 의해 D-메틸말로닐-CoA로 전환된다. 이 반응에는 중탄산염과 ATP가 필요하다.[27][8][19]
D-메틸말로닐-CoA는 메틸말로닐-CoA 에피머화효소에 의해 L-메틸말로닐-CoA로 전환된다.[27][8][19]
L-메틸말로닐-CoA는 메틸말로닐-CoA 뮤테이스에 의해 시트르산 회로의 대사 중간생성물인 석시닐-CoA로 전환된다. 메틸말로닐-CoA 뮤테이스는 탄소-탄소 결합의 치환기들의 위치 이동을 촉매하기 위해 코발라민을 필요로 하는 효소이다.[27][8][19]
메틸말로닐-CoA 뮤테이스의 작용 기작은 다음과 같다.
# 5'-디옥시아데노실의 5' CH2−와 3+의 산화 상태(III)인 코발트(Co) 사이의 결합이 분해된다. 이를 통해 중간생성물로 5'-디옥시아데노실 라디칼과 환원된 Co(II) 산화 상태의 코발라민이 생성된다.[27][8]
# 5'-디옥시아데노실 라디칼은 메틸말로닐-CoA의 메틸기로부터 수소 원자를 뺏어서 5'-디옥시아데노신을 형성하고, 메틸말로닐-CoA는 메틸말로닐-CoA 라디칼을 형성하게 된다.[27][8]
# 이러한 라디칼은 조효소와 탄소-코발트 결합을 형성하게 하고, 이어서 기질의 탄소 골격이 재배열되어 석시닐-CoA 라디칼이 생성되는 것으로 여겨진다.[27][8]
# 석시닐-CoA 라디칼은 이어서 이전에 생성된 5'-디옥시아데노신으로부터 수소를 뺏어서 석시닐-CoA를 형성하고, 5'-디옥시아데노신은 5'-디옥시아데노실 라디칼을 형성하게 된다. 5'-디옥시아데노실 라디칼은 조효소를 공격하여 초기 복합체를 재형성하게 된다.[27][8]
메틸말로닐-CoA 뮤테이스의 결합은 혈액의 pH를 감소시키는 위험한 이상 질환인 메틸말론산혈증을 유발한다.[27][8][19]
3. 2. 메틸시트르산 회로

프로피오닐-CoA의 축적은 생물에 독성을 나타낼 수 있다. 프로피오닐-CoA가 피루브산으로 전환되는 다른 회로들이 제안되었는데, 그 중 하나는 메틸시트르산 회로이다. 초기 반응은 β 산화되어 프로피오닐-CoA를 형성하며, 프로피오닐-CoA는 회로에서 추가로 분해된다. 메틸시트르산 회로는 시트르산 회로와 관련된 효소들을 포함하고 있다. 이들은 모두 유해한 프로피오닐-CoA로부터 세균을 보호하기 위한 전반적인 반응에 기여한다. 또한 메틸시트르산 회로는 미코박테리아에서 지방산의 이화작용으로 인한 경로로 간주된다.[22] 대사를 진행시키기 위해 prpC 유전자는 메틸시트르산 생성효소를 발현시키고, 만약 존재하지 않으면 메틸시트르산 회로는 진행되지 않을 것이다. 대신에 이화작용은 프로피오닐-CoA 카복실화효소를 통해 진행된다.[26] 이러한 메커니즘은 참여하는 반응물, 생성물, 중간생성물, 효소와 함께 왼쪽에 표시되어 있다.
4. 세균의 물질대사
세균에서 프로피오닐-CoA의 대사는 종에 따라 다르게 나타나며, 세포 내 항상성 유지 및 독성 물질 제거에 중요한 역할을 한다.
결핵균( ''Mycobacterium tuberculosis'')의 경우, 프로피오닐-CoA 축적은 독성을 유발할 수 있다. 결핵균에서 프로피오닐-CoA 대사는 세포벽 생성과 관련이 있으며, 이 과정이 없을 경우 세포는 다양한 독소 및 대식세포의 항균 작용에 취약해진다. 또한, 메틸시트르산 회로는 홀수 지방산의 β 산화로 생성되는 프로피오닐-CoA의 잠재적 독성을 완화하는 완충 작용을 한다.[30]
로도박터 스파에로이데스에서는 프로피오닐-CoA 축적이 피루브산 탈수소효소를 저해하여 치명적인 결과를 초래할 수 있다.[23] 대장균과 유사하게, 미코박테리아 종에서 프로피오닐-CoA는 즉시 처리되지 않으면 독성을 나타내며, 이는 세균의 세포벽을 구성하는 지질 관련 경로와 연관된다.[23] 긴 사슬 지방산을 에스터화하여 트라이아실글리세롤 형태로 저장함으로써 프로피오닐-CoA 농도를 조절할 수 있다.[23]
대장균에서 프로피오닐-CoA 대사는 3-하이드록시프로피온산 생성을 유도할 수 있다. 숙시네이트 CoA-전달효소 돌연변이는 3-하이드록시프로피온산 생성을 크게 증가시킨다.[26] 그러나 이와 관련된 정보는 아직 제한적이다.[31]
4. 1. 결핵균의 물질대사
결핵균( ''Mycobacterium tuberculosis'')에서 피루브산을 형성하기 위한 프로피오닐-CoA의 산화는 결핵균의 필요에 의해 영향을 받는다. 프로피오닐-CoA가 축적되면 독성을 나타낼 수 있다. 결핵균에서 프로피오닐-CoA의 대사는 세포벽 생성에 관여하는 것으로 제안되었다.[30] 따라서 이러한 이화작용이 없으면 다양한 독소, 특히 대식세포의 항균 메커니즘에 대한 세포의 감수성이 증가한다. 결핵균에서 프로피오닐-CoA의 운명에 관한 또 다른 가설은 프로피오닐-CoA가 홀수 지방산의 β 산화에 의해 생성되므로, 메틸시트르산 회로는 완충 메커니즘으로 작용하여 임의의 잠재적 독성을 상쇄하기 위해 후속적으로 활성화된다는 것이다.[30]4. 2. 로도박터 스파에로이데스에서의 격리 가능성
로도박터 스파에로이데스에서 프로피오닐-CoA 축적에 의한 피루브산 탈수소효소 저해는 치명적일 수 있다.[23] 대장균과 마찬가지로 미코박테리아 종에서 프로피오닐-CoA 유입은 즉시 처리하지 않으면 독성을 초래할 수 있는데, [23] 이러한 독성은 세균의 세포벽을 형성하는 지질과 관련된 경로에 의해 발생한다.[23] 긴 사슬 지방산의 에스터화를 이용하여 과량의 프로피오닐-CoA를 격리하고, 트라이아실글리세롤로 저장하여 프로피오닐-CoA의 상승 정도를 조절할 수 있다.[23] 이러한 지방산의 메틸 분지 과정은 이들이 프로피오닐-CoA를 축적하는 역할을 하게 한다.[23]4. 3. 대장균의 물질대사
루오(Luo) 등이 수행한 연구에서, 대장균은 프로피오닐-CoA의 대사가 어떻게 잠재적으로 3-하이드록시프로피온산의 생성을 유도할 수 있는지를 조사하기 위해 이용되었다. 경로에 관여하는 핵심 유전자인 숙시네이트 CoA-전달효소의 돌연변이가 3-하이드록시프로피온산을 크게 증가시키는 것으로 나타났다.[26] 그러나 이 분야는 여전히 발전 중인 분야로, 이 주제에 대한 정보는 제한적이다.[31]
5. 식물의 물질대사
식물에서 아미노산 대사는 특정 경로에 대한 확실한 증거가 부족해 논란이 많은 주제이다. 그러나 식물 아미노산 대사에 프로피오닐-CoA 생성 및 사용과 관련된 효소가 관여한다는 주장이 제기되었다. 프로피온산은 프로피오닐-CoA 형태로 존재하기 때문에, 프로피오닐-CoA는 퍼옥시좀의 β 산화 경로를 통해 β-하이드록시프로피온산으로 전환된다.[32]
식물과 곤충에서 프로피오닐-CoA는 β 산화와 유사한 다른 경로를 통해 아세트산으로 대사된다. 이 경로의 세부 사항은 모두 밝혀지지 않았지만, 아크릴릴-CoA와 3-하이드록시프로피오닐-CoA가 생성되는 것으로 알려져 있다. 이 대사 과정에서 3-하이드록시프로피오닐-CoA의 1번 탄소는 이산화 탄소가 되고, 3번 탄소는 아세트산의 1번 탄소가 된다.
5. 1. 아이소뷰티릴-CoA 대사와의 관련성
아이소뷰티릴-CoA는 프로피오닐-CoA와 관련이 있으며, 이 둘은 발린 대사의 중간생성물로 간주된다. 프로피온산은 프로피오닐-CoA 형태로 존재하기 때문에, 프로피오닐-CoA는 퍼옥시좀의 베타 산화 경로를 통해 β-하이드록시프로피온산으로 전환된다.[32] 애기장대에서는 발린을 프로피오닐-CoA로 전환시키는 주요 효소가 관찰되지 않았지만, 루카스(Lucas) 등의 실험에서 퍼옥시좀 효소를 통해 프로피오닐-CoA 및 아이소뷰티릴-CoA가 발린뿐만 아니라 다른 여러 기질들의 대사에도 관여하는 것으로 밝혀졌다.[32]
6. 균류의 물질대사
지방산의 이화작용을 통한 프로피오닐-CoA 생성은 싸이오에스터화와 관련이 있다. 아스페르길루스 니둘란스(''Aspergillus nidulans'')에 관한 연구에서, 메틸시트르산 생성효소 유전자인 mcsA의 억제로 별개의 폴리케타이드의 생성이 억제되는 것으로 밝혀졌다.[33] 따라서 메틸시트르산을 통한 프로피오닐-CoA의 사용은 프로피오닐-CoA의 농도를 감소시키는 동시에, 폴리케타이드의 농도를 증가시킨다. 폴리케타이드는 아세틸-CoA 및 말로닐-CoA로 만들어지고 균류에서 흔히 발견되는 구조이다. 폴리케타이드는 식물에 병원성을 나타내는 균류를 통해 농업 작물에 대한 폴리케타이드의 독성을 제한함으로써 의약적으로나 잠재적으로 해로운 속성에 대한 연구를 증가시키게 한 특성들을 가지고 있다.[33]
지방산 이화 작용을 통한 프로피오닐-CoA의 생성은 티오에스터화와 관련이 있다는 점은 앞의 내용과 동일하다. ''Aspergillus nidulans''(애스퍼질러스 니둘란스)에 관한 연구에서, 메틸시트르산 합성 효소 유전자 ''mcsA''를 억제하자, 특정 폴리케타이드의 생성 또한 억제되는 것을 발견했다. 따라서 메틸시트르산 회로를 통한 프로피오닐-CoA의 활용은 그 농도를 감소시키고, 결과적으로 폴리케타이드의 농도를 증가시킨다. 폴리케타이드는 곰팡이에서 흔히 발견되는 구조로, 아세틸기와 말로닐-CoA로 구성되어 있으며, 교대로 카르보닐기와 메틸렌기를 갖는 산물을 제공한다. 폴리케타이드와 폴리케타이드 유도체는 종종 구조적으로 매우 복잡하며, 일부는 독성이 강하다. 이로 인해 식물 병원성 곰팡이를 통해 농업에서 폴리케타이드 독성을 제한하는 연구가 진행되었다.[14]
7. 단백질 프로피오닐화
사람의 아세틸기전이효소인 Gen5는 프로피오닐-CoA 및 뷰틸 사이아노아크릴레이트와 결합하는데, 이들은 GCN5L2의 촉매 도메인에 특이적으로 결합한다. 이렇게 보존된 아세틸기전이효소는 히스톤의 N-말단 꼬리의 리신 잔기의 아세틸화에 의한 전사 조절을 담당한다. 이러한 아세틸화 작용은 프로피오닐화 또는 뷰티릴화보다 반응 속도가 훨씬 빠르다. 프로피오닐-CoA의 구조로 인해 Gen5는 서로 상이한 아실-CoA 분자들을 구별한다. 뷰티릴-CoA의 프로필기는 불포화된 아실 사슬로 인해 Gen5의 활성 부위에 대한 입체특이성이 부족하기 때문에 결합할 수 없다는 것이 밝혀졌다. 반면에 프로피오닐-CoA의 3번 탄소는 정확한 방향으로 Gen5의 활성 부위로 들어갈 수 있다.[34]
프로피오닐-CoA는 단백질의 번역 후 변형의 기질로서, 단백질의 리신 잔기와 반응하여 단백질 프로피오닐화를 일으킨다.[15][16] 아세틸-CoA와 프로피오닐-CoA의 구조적 유사성으로 인해, 프로피오닐화 반응은 단백질 아세틸화에 사용되는 많은 효소를 사용할 것으로 생각된다.[6] 단백질 프로피오닐화의 기능적 결과는 현재 완전히 이해되지 않았지만, 시험관 내 프로피오닐-CoA 합성효소 효소의 프로피오닐화는 그 활성을 조절한다.[17]
8. 사람에 대한 임상적 중요성
프로피오닐-CoA는 사람의 생리 활성에 관여하며, 그 기능에 이상이 생기면 여러 질병을 일으킬 수 있다.
프로피오닐-CoA 카복실화효소의 결핍으로 인한 프로피온산혈증은 신생아에게 발달 장애, 정신 장애 등을 유발할 수 있다. 이는 프로피오닐-CoA가 메틸말로닐-CoA로 전환되지 못하고 축적되기 때문이다. 신생아들은 높은 프로피오닐카르니틴 수치에 대한 검사를 받으며, 소변 검사를 통해 질병을 진단할 수 있다. 반복되는 증상을 완화하고 예방하기 위해 프로피온산 생성을 줄이는 보충제를 사용하기도 한다.[24][5]
8. 1. Gen5
사람의 아세틸기전이효소인 Gen5는 프로피오닐-CoA 및 뷰틸 사이아노아크릴레이트와 결합하는데, 이들은 GCN5L2의 촉매 도메인에 특이적으로 결합한다.[34] 이 아세틸기전이효소는 히스톤의 N-말단 꼬리의 리신 잔기의 아세틸화에 의한 전사 조절을 담당한다.[34] 아세틸화 작용은 프로피오닐화나 뷰티릴화보다 반응 속도가 훨씬 빠르다.[34] Gen5는 프로피오닐-CoA의 구조로 인해 서로 다른 아실-CoA 분자들을 구별한다.[34] 뷰티릴-CoA의 프로필기는 불포화된 아실 사슬로 인해 Gen5 활성 부위에 대한 입체특이성이 부족하여 결합할 수 없다.[34] 반면 프로피오닐-CoA의 3번 탄소는 정확한 방향으로 Gen5의 활성 부위로 들어갈 수 있다.[34]8. 2. 프로피온산혈증
프로피오닐-CoA 카복실화효소의 결핍으로 인한 프로피온산혈증은 신생아의 발달 단계에서 장애, 정신 장애 등 여러 가지 문제를 일으킬 수 있다. 이는 프로피오닐-CoA가 메틸말로닐-CoA로 전환될 수 없어 프로피오닐-CoA가 축적되기 때문이다. 신생아들은 높은 프로피오닐카르니틴 수치에 대한 검사를 받으며, 소변 검사를 통해 질병을 진단할 수 있다. 반복되는 증상을 완화하고 예방하기 위해 프로피온산 생성을 줄이는 보충제를 사용하기도 한다.[24][5]참조
[1]
서적
Biotin and Other Interferences in Immunoassays
Elsevier
2019-01-01
[2]
저널
Propionyl-CoA carboxylase - A review
2017-12-01
[3]
저널
Role of the methylcitrate cycle in propionate metabolism and detoxification in Mycobacterium smegmatis
2007-12-01
[4]
저널
Loving the poison: the methylcitrate cycle and bacterial pathogenesis
2018-03-01
[5]
서적
GeneReviews®
University of Washington, Seattle
2019-06-13
[6]
저널
Mechanism of formation of bile acids from cholesterol: oxidation of 5bita-choles-tane-3alpha,7alpha,12alpha-triol and formation of propionic acid from the side chain by rat liver mitochondria
http://www.jbc.org/c[...]
2019-09-25
[7]
저널
Production of 3-Hydroxypropionic Acid via the Propionyl-CoA Pathway Using Recombinant Escherichia coli Strains
2016-05-26
[8]
저널
Comparative aspects of propionate metabolism
1989-01-01
[9]
저널
The Nitrogen Regulator GlnR Directly Controls Transcription of the prpDBC Operon Involved in Methylcitrate Cycle in Mycobacterium smegmatis
2019-04-01
[10]
저널
Coupling Krebs cycle metabolites to signalling in immunity and cancer
2019-01-01
[11]
저널
Role of the methylcitrate cycle in Mycobacterium tuberculosis metabolism, intracellular growth, and virulence
2006-06-01
[12]
저널
Multiple propionyl coenzyme A-supplying pathways for production of the bioplastic poly(3-hydroxybutyrate-co-3-hydroxyvalerate) in Haloferax mediterranei
https://archive.org/[...]
2013-05-01
[13]
저널
Peroxisomal metabolism of propionic acid and isobutyric acid in plants
2007-08-01
[14]
저널
Connection of propionyl-CoA metabolism to polyketide biosynthesis in Aspergillus nidulans
2004-10-01
[15]
저널
Lysine propionylation and butyrylation are novel post-translational modifications in histones
2007-05-01
[16]
저널
Molecular characterization of propionyllysines in non-histone proteins
2009-01-01
[17]
저널
N-lysine propionylation controls the activity of propionyl-CoA synthetase
2007-10-01
[18]
저널
Structural basis for acyl-group discrimination by human Gcn5L2
2016-07-01
[19]
웹사이트
メチルマロン酸血症
http://www.nanbyou.o[...]
難病医学研究財団/難病情報センター
2010-10-31
[20]
서적
Biotin and Other Interferences in Immunoassays
Elsevier
2019-01-01
[21]
저널
Propionyl-CoA carboxylase - A review
2017-12-01
[22]
저널
Role of the methylcitrate cycle in propionate metabolism and detoxification in Mycobacterium smegmatis
2007-12-01
[23]
저널
Loving the poison: the methylcitrate cycle and bacterial pathogenesis
2018-03-01
[24]
서적
GeneReviews®
University of Washington, Seattle
2019-06-13
[25]
저널
Mechanism of formation of bile acids from cholesterol: oxidation of 5bita-choles-tane-3alpha,7alpha,12alpha-triol and formation of propionic acid from the side chain by rat liver mitochondria
http://www.jbc.org/c[...]
2019-09-25
[26]
저널
Production of 3-Hydroxypropionic Acid via the Propionyl-CoA Pathway Using Recombinant Escherichia coli Strains
2016-05-26
[27]
저널
Comparative aspects of propionate metabolism
1989-01-01
[28]
저널
The Nitrogen Regulator GlnR Directly Controls Transcription of the prpDBC Operon Involved in Methylcitrate Cycle in Mycobacterium smegmatis
2019-04-01
[29]
저널
Coupling Krebs cycle metabolites to signalling in immunity and cancer
2019-01-01
[30]
저널
Role of the methylcitrate cycle in Mycobacterium tuberculosis metabolism, intracellular growth, and virulence
2006-06-01
[31]
저널
Multiple propionyl coenzyme A-supplying pathways for production of the bioplastic poly(3-hydroxybutyrate-co-3-hydroxyvalerate) in Haloferax mediterranei
https://archive.org/[...]
2013-05-01
[32]
저널
Peroxisomal metabolism of propionic acid and isobutyric acid in plants
2007-08-01
[33]
저널
Connection of propionyl-CoA metabolism to polyketide biosynthesis in Aspergillus nidulans
https://archive.org/[...]
2004-10-01
[34]
저널
Structural basis for acyl-group discrimination by human Gcn5L2
2016-07-01
본 사이트는 AI가 위키백과와 뉴스 기사,정부 간행물,학술 논문등을 바탕으로 정보를 가공하여 제공하는 백과사전형 서비스입니다.
모든 문서는 AI에 의해 자동 생성되며, CC BY-SA 4.0 라이선스에 따라 이용할 수 있습니다.
하지만, 위키백과나 뉴스 기사 자체에 오류, 부정확한 정보, 또는 가짜 뉴스가 포함될 수 있으며, AI는 이러한 내용을 완벽하게 걸러내지 못할 수 있습니다.
따라서 제공되는 정보에 일부 오류나 편향이 있을 수 있으므로, 중요한 정보는 반드시 다른 출처를 통해 교차 검증하시기 바랍니다.
문의하기 : help@durumis.com